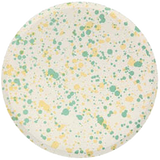

Speckled Side Plates
Item is in stock
Hurry! Low inventory
Item is out of stock
Item is unavailable
$8.50
off
Description
An easy way to get lots of color on your party table is to display plates with a mixture of shades. These fabulous speckled paper plates, in 4 colorways, look really stylish.
Crafted from high quality 450gsm paper
- Made from eco-friendly paper
- Pack of 8 in 4 colors
- Product dimensions: 8.5 x 8.5 x 0.25 inches
- Pack dimensions: 8.5 x 8.5 x 0.5 inches
Speckled Side Plates
$8.50